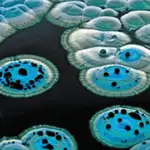
Diferentes etapas de las moléculas en un antibiótico

Salud Mental
El confinamiento, causa principal de ingresos psiquiátricos de corta duración
En los casos de personas con patologías mentales previas, la suspensión de consultas presenciales y terapias de grupo han sido fatales para su evolución.

Entre las principales consecuencias negativas que han traído consigo los periodos de confinamiento (aumento de los índices de sobrepeso y obesidad, sedentarismo, desprotección social a colectivos de riesgo, etc) el empeoramiento de la salud mental es la más preocupante. Trastornos como la ansiedad o la depresión han crecido un 20% entre la población general, y hasta un 80% entre los profesionales sanitarios. Se habla de que la pandemia de la Covid-19 desembocará en una de salud mental, para la que además el Sistema Nacional de Salud no está preparado. La escalada de problemas emocionales ha afectado a la gran mayoría de la población, en una medida u otra, con un especial impacto en personas con patologías mentales previas. En casos como el de los pacientes con esquizofrenia, la situación es especialmente preocupante ya que la frecuencia de las recaídas ha crecido exponencialmente.
Ahora,un nuevo estudio realizado entre los psiquiatras de más de 100 hospitales españoles, muestra que más de la mitad de estos profesionales señalan el confinamiento como la causa principal de los ingresos de nuevos pacientes en las Unidades de Hospitalización Breve (UHB) de Psiquiatría. “En las personas con problemas de salud mental, además de repercutir en mayor o menor medida el simple hecho de quedarse en casa, ha sido determinante en muchos casos los cambios en la atención ambulatoria. El hecho de que muchos seguimientos hayan pasado a hacerse vía telefónica o se hayan suspendido terapias de grupo y actividades de rehabilitación ha supuesto un retroceso en muchos pacientes”, explica doctor Roberto Rodríguez-Jiménez, jefe de la Unidad de Hospitalización de Psiquiatría del Hospital 12 de Octubre (Madrid) y coordinador de la V Jornada de Unidades de Hospitalización Breve de Psiquiatría, organizada por la Alianza Otsuka-Lundbeck.
Los efectos negativos de la teleasistencia
Y es que la atención presencial es clave en la salud mental, dado que el “cara a cara” entre paciente y terapeuta es uno de los principios básicos del tratamiento. “La teleasistencia favorece la prescripción de fármacos. El no acudir al especialista de manera presencial, provoca que no se pueda valorar la situación del modo más correcto, que es teniendo al paciente delante. Y ese uno de los motivos por los que el consumo de ansiolíticos y antidepresivos se está disparando”, explica José Ramón Ubieto, profesor colaborador de los Estudios de Psicología y Ciencias de la Educación de la Universidad Oberta de Catalunya
El trabajo muestra también que se observó una notable disminución de la demanda de atención urgente psiquiátrica durante el periodo de confinamiento, según han percibido el 74% de los encuestados. “La consecuencia de esto es evidentemente negativa sobre el estado de salud de aquellos que se ven especialmente beneficiados de una atención urgente”, señala el doctor José Martínez-Raga, también coordinador de la Jornada y psiquiatra del Hospital Universitario Doctor Peset (Valencia). Asimismo, como han constatado estos profesionales (65,6%), se han suspendido terapias complementarias. Las más afectadas han sido las terapias de grupo, las terapias ocupacionales y los programas psicoeducativos. Al respecto de esta información, el doctor Rodríguez-Jiménez recuerda que “el tratamiento no farmacológico es fundamental ya que complementa y que alguno de ellos actúa de manera sinérgica con el abordaje farmacológico”. “Así, la supresión temporal de buena parte de estas terapias ha tenido una repercusión clínica negativa en los pacientes que estamos intentando revertir”, insiste.
✕
Accede a tu cuenta para comentar

La estrategia de la derecha